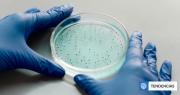
Qué implica para Occidente el ascenso científico de China

Tecnología
03 de noviembre de 2025 Página 1

VER RESUMEN Resumen generado con una herramienta de Inteligencia Artificial desarrollada por BioBioChile y revisado por el autor de este artículo. Un estudio publicado en la revista Science revela que los chimpancés poseen capacidades de pensamiento racional similares a las... + más
Amnistía: Los ataques aéreos lanzados por EEUU en América Latina son asesinatos | El Boyaldía
Editorial Mi Voz: Javiera Parada, ¿traición o convicción? | El Boyaldía

La nueva edición del Programa Internacional para Directoras de Empresas Innovadoras, impulsado por el Centro de Innovación UC Anacleto Angelini en conjunto con Women Board Up, dio inicio a sus actividades con la primera sesión realizada en las oficinas de Carey.Esta versión... + más
En Tortel lanzan programa que fortalece autonomía de mujeres Jefas de Hogar | El Divisadero
Mujeres del litoral se reúnen para potenciar liderazgos, emprendimiento y empoderamiento económico | El Divisadero

Tomar suplementos de melatonina de manera prolongada para combatir el insomnio podría no ser inocuo; según un estudio, las personas que toman este compuesto durante al menos un año son más propensas a sufrir insuficiencia cardíaca, a ser hospitalizados por ello y a morir... + más
Descubren que hongo intestinal influiría directamente en el consumo de alcohol, por medio del cerebro | BioBioChile
No solo resaca y deshidratación: Los peligrosos efectos que produce el exceso de alcohol en tu cuerpo | BioBioChile
VER RESUMEN Resumen generado con una herramienta de Inteligencia Artificial desarrollada por BioBioChile y revisado por el autor de este artículo. China ha emergido como una potencia científica global, liderando casi la mitad de las investigaciones conjuntas con Estados... + más
China amplía periodo de exención de visa para turistas de Chile y otros 4 países sudamericanos | BioBioChile
Litio retoma senda alcista tras cambios en la política industrial de China, pero persiste cautela por exceso de oferta | Diario Financiero

VER RESUMEN Resumen generado con una herramienta de Inteligencia Artificial desarrollada por BioBioChile y revisado por el autor de este artículo. La USS y el CECs instalaron el primer microscopio confocal 4D de América Latina en Valdivia, posicionando a Chile en la... + más
Instalan en Valdivia el microscopio más avanzado de Latinoamérica: potenciará investigaciones en Chile | BioBioChile
Colegio Los Leones grita campeón de Copa Chile de Básquetbol en Valdivia: superó a locales en final | BioBioChile

Las “Charlas del Futuro 2020”, son una serie de 60 episodios de entre 20 y 30 minutos de duración, en su audio original y subtitulados al español, que, gracias al trabajo conjunto entre Fundación VTR, Fundación Encuentros del Futuro y el Senado de Chile, pondrán a... + más
Congreso Regional Explora reunió a la comunidad educativa de Aysén en torno a las ciencias y la innovación | El Divisadero
Más de 200 marcas se reúnen en la versión 17 del Bazar ED, feria barómetro del consumo de estilo y creatividad en Chile | Diario Financiero

La decisión, presentada durante su evento Upfront para anunciantes, busca capitalizar el prestigio de HBO en medio de un mercado saturado y competitivo. (CNN) – Max tiene nuevo nombre… otra vez. Desde el escenario de la presentación Upfront de Warner Bros. Discovery (WBD)... + más
“Hello Kitty” da el gran salto de la mano de Warner Bros. y llegará a los cines | ADN

Halloween, o conocida también como la Noche de Brujas, es una de las jornadas más esperadas por los niños, trae consigo un elevado consumo de dulces que, según advierten los expertos, representa una potencial amenaza para la salud dental. Si bien la celebración en sí misma... + más
Chucky y Freddy Fazbear protagonizan edición limitada de Fanta y terrorífico videojuego por Halloween | BioBioChile
Chucky y Freddy Fazbear protagonizan edición limitada de Fanta y terrorífico videojuego por Halloween | BioBioChile

Científicos del Centro de Fertilidad de la Universidad de Columbia (Estados Unidos) notificaron el primer embarazo concretado gracias a un procedimiento guiado por Inteligencia Artificial (IA). Este método, diseñado específicamente para la recuperación de esperma, se dirige... + más
Alternativas de fertilidad para parejas del mismo género: nuevas formas de hacer familia | BioBioChile
La IA logró el primer embarazo en caso de infertilidad masculina: identificó los espermatozoides sanos | BioBioChile

VER RESUMEN Resumen generado con una herramienta de Inteligencia Artificial desarrollada por BioBioChile y revisado por el autor de este artículo. La ballena boreal, uno de los mamíferos más longevos, puede llegar a vivir más de 200 años, posiblemente, gracias a su mayor... + más
¿Por qué la ballena boreal vive 200 años? Científicos creen haber encontrado la respuesta en su ADN | BioBioChile
Sospechosos por el robo del Louvre no responden al perfil del crimen organizado | Cooperativa

Fue en los años 80 que un científico nacido en la Patagonia Chilena propuso que el Alzhaimer se origina por una modificación de la proteína TAU. Esto sentó las bases en el mundo de la ciencia y la investigación moderna sobre la enfermedad. Con más de 50 años de... + más
Sospechosos por el robo del Louvre no responden al perfil del crimen organizado | Cooperativa
DF Lab Opinión / Telecomunicaciones: confianza y transformación tecnológica | Diario Financiero

Un emotivo momento vivió la jurado del programa televisivo de Chilevisión, Yo Soy, Fran García-Huidobro tras la presentación de la imitadora de Rocío Jurado. “Esta señora me ha hecho llorar cuatro meses. Creo fervientemente que la música tiene que hacer eso: generar... + más
Se lució: Hermana de Fran Maira impactó con su parecido a la cantante en el Miss Mundo | ADN
Es muy linda: Hermana de Fran Maira captó las miradas en Miss Mundo Chile | 24 Horas

Hoy nos enfrentamos con un nuevo escenario, lleno de incertidumbres en lo económico, social y político, que afectará nuestras vidas por mucho tiempo y en el que ninguna de las recetas del pasado parece funcionar. Las consecuencias de la pandemia y de los grandes cambios... + más
Innovar en salud: Chile no puede esperar para transformar la atención de miles de personas | Diario Uchile
Innovación en regiones: una oportunidad para el desarrollo de Chile | El Boyaldía

Cuando hablamos de innovación en Chile, con frecuencia lo hacemos desde una mirada centrada en los polos tradicionales de desarrollo. Sin embargo, las oportunidades de transformación regional también están —y muchas veces con una urgencia particular— en otros territorios... + más
Innovar en salud: Chile no puede esperar para transformar la atención de miles de personas | Diario Uchile
Resumen: Coquimbo Unido selló su ansiado título y levantó la copa | Cooperativa
La Cámara Chilena de la Construcción (CChC) y el Centro Nacional de Inteligencia Artificial (CENIA) presentaron este miércoles Revi: Permisos con IA, una innovadora herramienta tecnológica desarrollada en alianza con las municipalidades de Maipú y Providencia. El proyecto... + más
OTIC CChC premia a los 50 líderes que impulsan el talento y la formación en Chile | El Boyaldía
Cuarenta mujeres acceden a mamografía en operativo de detección precoz del cáncer de mama | El Divisadero
La lentitud de los pagos internacionales se ha convertido en un desafío crítico para las empresas chilenas, en especial para aquellas que importan insumos desde Asia y Estados Unidos. Mientras el e-commerce nacional sigue en expansión, los tradicionales tres a siete días... + más
Cámara aprobó “Ley Tommy Rey”: plataformas digitales y streaming deberán pagar | Diario Uchile
Música chilena gana batalla digital en la Cámara: aprueban la Ley Tommy Rey y pasa al Senado | BioBioChile

VER RESUMEN Resumen generado con una herramienta de Inteligencia Artificial desarrollada por BioBioChile y revisado por el autor de este artículo. Astrónomos del Observatorio Europeo Austral (ESO) en Chile han avistado a través de un telescopio una enorme nube de gas y polvo... + más
Conjunciones planetarias y una Superluna: este es el calendario astronómico de noviembre de 2025 | BioBioChile
Resumen: Coquimbo Unido selló su ansiado título y levantó la copa | Cooperativa

VER RESUMEN Resumen generado con una herramienta de Inteligencia Artificial desarrollada por BioBioChile y revisado por el autor de este artículo. La USS y el CECs instalaron el primer microscopio confocal 4D de América Latina en Valdivia, posicionando a Chile en la... + más
Instalan en Valdivia el microscopio más avanzado de Latinoamérica: potenciará investigaciones en Chile | BioBioChile
Colegio Los Leones grita campeón de Copa Chile de Básquetbol en Valdivia: superó a locales en final | BioBioChile

VER RESUMEN Resumen generado con una herramienta de Inteligencia Artificial desarrollada por BioBioChile y revisado por el autor de este artículo. La NASA ha dejado de actualizar sus plataformas digitales debido al cierre del gobierno federal en Estados Unidos por falta de... + más
¿Por qué la NASA dejó de informar sobre el cometa 3I/ATLAS teniendo la mejor nave para observarlo? | BioBioChile
Sigue sorprendiendo: el cometa 3I/ATLAS mostró un inusual brillo azul al acercarse al Sol | BioBioChile

Este miércoles, el país marcó un hito en el desarrollo tecnológico regional con el lanzamiento de Copuchat, una plataforma gratuita y abierta que servirá como la interfaz clave para la construcción de LatamGPT, el primer modelo de lenguaje de Inteligencia Artificial (IA)... + más
Resumen: Coquimbo Unido selló su ansiado título y levantó la copa | Cooperativa
Álvaro Soto, director del Centro Nacional de Inteligencia Artificial (CENIA): “Tenemos que desarrollar nuestra propia infraestructura de cómputo para IA” | Diario Financiero

VER RESUMEN Resumen generado con una herramienta de Inteligencia Artificial desarrollada por BioBioChile y revisado por el autor de este artículo. La ballena boreal, uno de los mamíferos más longevos, puede llegar a vivir más de 200 años, posiblemente, gracias a su mayor... + más
¿Por qué la ballena boreal vive 200 años? Científicos creen haber encontrado la respuesta en su ADN | BioBioChile
Sospechosos por el robo del Louvre no responden al perfil del crimen organizado | Cooperativa

Cambia el mundo, pero algo seguirá: la necesidad de integranos a escala global. Qué nos diferencia es una posibilidad para complementarnos y potenciarnos entre todos con mayor y mejor colaboración. La Nueva India es el libro publicado por el embajador, ex ministro y... + más
Resumen: Coquimbo Unido selló su ansiado título y levantó la copa | Cooperativa
Newsletter: Chile y el cobre ante la agresión de Trump | El Boyaldía

La explosión del comercio electrónico y la alta demanda por servicios inmediatos en hotelería han generado un desafío creciente: la congestión en conserjerías, el exceso de paquetes y la necesidad de entregas rápidas y precisas. Según la Cámara de Comercio de Santiago... + más
Vuelco en caso: Detienen a cuñado de víctima por muerte de fotógrafo y sus dos hijos en La Reina | Cooperativa

VER RESUMEN Resumen generado con una herramienta de Inteligencia Artificial desarrollada por BioBioChile y revisado por el autor de este artículo. La NASA ha dejado de actualizar sus plataformas digitales debido al cierre del gobierno federal en Estados Unidos por falta de... + más
¿Por qué la NASA dejó de informar sobre el cometa 3I/ATLAS teniendo la mejor nave para observarlo? | BioBioChile
Sigue sorprendiendo: el cometa 3I/ATLAS mostró un inusual brillo azul al acercarse al Sol | BioBioChile
Notibol. Desde 2006. Central de Noticias.
Notibol es un agregador informático de noticias y no es responsable del contenido de los enlaces a los sitios externos que generan las noticias.
Acerca de Notibol | Contacto | Política de Privacidad | Descargo de Responsabilidad